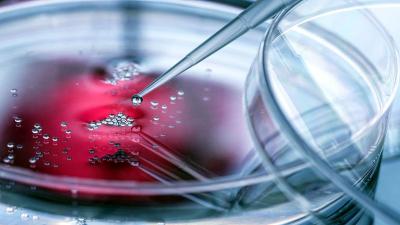

Future Human : वृद्धत्व जाणार, बुद्धिमत्ता वाढणार, १०० वर्षात २० बदल होणार, असा दिसेल भविष्यातील मानव
By ऑनलाइन लोकमत | Updated: February 2, 2023 13:26 IST2023-02-02T13:20:00+5:302023-02-02T13:26:41+5:30
Future Human: गेल्या हजारो वर्षांत मानव हा सातत्याने उत्कांत आणि विकसित होत आला आहे. या काळात मानवामध्ये अनेक शारीरिक बदल झाले आहेत. ही प्रक्रिया अजूनही सुरू आहे. त्यामुळे आता भविष्यात आपले वंशज कसे दिसतील, याबाबतची उत्सुकता आपल्याला असते. याचं उत्तर विज्ञानाद्वारे आपल्यासमोर आहे. त्यातून पुढील मानव कसा असेल, याची माहिची समोर आली आहे.

गेल्या हजारो वर्षांत मानव हा सातत्याने उत्कांत आणि विकसित होत आला आहे. या काळात मानवामध्ये अनेक शारीरिक बदल झाले आहेत. ही प्रक्रिया अजूनही सुरू आहे. त्यामुळे आता भविष्यात आपले वंशज कसे दिसतील, याबाबतची उत्सुकता आपल्याला असते. याचं उत्तर विज्ञानाद्वारे आपल्यासमोर आहे. त्यातून पुढील मानव कसा असेल, याची माहिची समोर आली आहे.

भविष्यात मानवी शरीर अधिक लवचिक होईल. अफघात, पडणे, आपटणे यामुळे आपले शरीर सातत्याने विकसित होत आहे. त्यामुळे भविष्यात आपलं शरीर हे अधिक लवचिक होईल. हाडं मजबूत होतील. तसेच कार्टिलेजमुळे दुखापतीही कमी होतील.

मानवाचे दात भविष्यात चोचीसारखे होतील, असा अंदाज शेफिल्ड विद्यापीठाचे बायोलॉजिस्ट गॅरेथ फ्रेजर यांनी व्यक्त केला आहे. भविष्यात मानवाचे दात एकमेकांमध्ये मिळून जातील. खानपान पद्धतीमुळे हा विकास होणार आहे.

भविष्यात मानव अधिक उंच होईल. गेल्या १०० वर्षांत माणसांची सरासरी उंची वाढली आहे. पुढील १०० वर्षांमध्येही असाच विकास होण्याची शक्यता आहे.

भविष्यात माणसाला कमी ऑक्सिजन असलेल्या ठिकाणी अनुकूलन साधण्यासाठी अधिक ऑक्सिजन खेचू शकणाऱ्या फुप्फुसांची आणि स्नायूंची गरज भासणार आहे. भविष्यात ही व्यवस्था जेनेटिक इंजिनियरिंगच्या माध्यमातूनही होईल.

भविष्यामध्ये मानवाची बोटे अधिक लांब आणि लवकिच होती. त्यामधील अचुकता वाढेल. त्याचा फायदा टायपिंग आणि टचस्क्रिन यंत्रांना ऑपरेट करताना होणार आहे.

सध्या आपण दररोज नव्या आणि अधिकाधिक डेटाचा सामना करत आहोत. पुढच्या वर्षात याची मात्रा वाढेल. त्यामुळे या सर्व माहितीची साठवण करण्यासाठी मेंदूही अधिकाधिक विकसित होत जाईल. त्यामुळे अधिक गोष्टी लक्षात ठेवता येतील. मात्र त्यामुळे काही मानसिक बदलही होतील.

भविष्यात अनुवांशिक आजार कमी होतील. ऐकण्याची क्षमता वाढेल, दृष्टीहीनांची संख्या कमी होईल. तांत्रिक विकासामुळे अंध आणि कर्णबधीरांना नवं जीवन मिळेल. तसेच लोकांना अंधारामध्येही अधिक स्पष्टपणे दिसू लागेल.

जेनेटिक इंजिनियरिंगमुळे फायदा होईल. मात्र त्याचे काही तोटेही दिसून येतील. चांगल्या आरोग्याचा अर्थ नव्या आजारांचाही सामना करावा लागेल. कारण पर्यावरणही बदलत आहे. त्यामुळे अधिक प्रमाणावर अॅलर्जी होईल. इम्युनिटी वाढवणाऱ्या गोष्टींपासून आपण दूर जाऊ. मात्र त्या काळातील समाजामध्ये शक्तिशाली इम्युनिटीची गरज कदाचित भासणार नाही.

इव्होल्युशनरी एंथ्रोपोलॉजिस्टमधील संशोधक कॅडेल लास्ट यांनी दिलेल्या माहितीनुसार मानव हळूहळू लैंगिक परिपक्वता प्राप्त करेल. बायोलॉजिकल रिप्रॉडक्शन काहीसं उशिरा होईल. मात्र याचा अर्थ मुलं उशिरा होतील, असा नाही. तर मानव संथगतीने जीवन व्यतिक करेल, तसेच अधिक वृद्ध होऊन मृत्य पावेल.

लेंसेटमध्ये प्रसिद्ध झालेल्या एका रिपोर्टनुसार गेल्या १०० वर्षांमध्ये विकसित देशांमध्ये लोक अधिकाधिक लठ्ठ होत असल्याचे दिसून येत आहे. त्यामुळे भविष्यात प्रत्येक देशातील लोक हे लठ्ठ होतील आणि लठ्ठपणा ही एक गंभीर समस्या म्हणून समोर येईल.

फ्युचरिस्ट इयान पीयर्सन यांनी सांगितले की, आमचा मेंदू हा संगणकाप्रमाणे काम करू लागेल. २०५० पर्यंत हे दिसू लागेल. २०७५ पर्यंत अनेक विकसित देशांमध्ये लोक मशीन ऑगमेंटेशनचा वापर करू लागतील.
मानव दुसऱ्या ग्रहावर जाऊन राहू लागेल. अशा परिस्थितीत तिथे टिकून राहण्यासाठी मानवी शरीरातील पेशींना जेनेटिकली मॉडिफाईड करावे लागेल. मंगळ ग्रहावर राहण्यासाठी याची अधिक आवश्यकता भासेल.

भविष्यामध्ये अनुवांशिक आजार संपुष्टात येतील. त्यामध्ये सिस्टिक फायब्रोसिस, हटिंग्टन सिंड्रोम आदी आजारांचा समावेश आहे. कारण त्यावरील उपचार हे जेनेटिक इंजिनियरिंगद्वारे होतील.

भविष्यात मानवाला आपल्या आठवणी डाऊनलोड करता येतील. म्हणजेच तुम्ही तुमच्याकडील आठवणी पेन ड्राइव्ह किंवा मेमरीकार्डमध्ये डाऊनलोड करू शकाल. याबाबत एमआयटीमध्ये उंदरांवर यशस्वी प्रयोग करण्यात आला आहे. तसेच मानव आपल्या डोक्यातील आठवणी दुसऱ्याच्या डोक्यात किंवा दुसऱ्याच्या डोक्यातील आठवणी आपल्या डोक्यात टाकू शकेल.

जेव्हा मानवाचा स्वभाव बदलेल तेव्हा स्वभावानुसार मानवाच्या त्वचेचा रंगही बदलेल. जसा सरड्याच्या त्वचेचा रंग बदलतो. तसा मानवाच्या त्वचेचा रंग बदलेल. ही गोष्ट काही प्रमाणात आजही होते. जेव्हा लाजून माणूस गुलाबी होतो.

वातावरणतज्ज्ञ मॅथ्यू हबर यांच्या म्हणण्यानुसार ग्लोबल वॉर्मिंगमुळे तापमान वाढत आहेत. माणूस विकसित होऊन अधिक मजबूत होईल, तेव्हा अधिक तापमान सहन करू शकेल. अधिक गरम भागात राहण्याची सवय करावी लागेल. अशा गरम भागासोबत मानव स्वत:ला जुळवून घेईल.

सध्या वय कमी करण्याच्या तंत्रावर अधिक संशोधन केले जात आहे. कारण वृद्धत्व ही एक शारीरिक प्रक्रिया नाही तर आजारपण आहे. ती दुरुस्त करता येऊ शकते. त्यानंतर लोक अधिक तरुण दिसू लागतील. ५०-६० वर्षांच्या व्यक्ती ३०-४० वर्षांच्या दिसू लागतील.

मानव अमर होईल - अमर होण्याचा अर्थ असा नाही की, मानव नेहमी जिवंत राहील. तर तांत्रिक पद्धतीने आर्टिफिशिल इंटेलिजन्सच्या माध्यमातून मानवाला जिवंत ठेवलं जाईल. मानवाच्या बुद्धिमत्तेला आपल्या रूपात सांभाळून ठेवलं जाईल.

मानव कायम स्वरूपी जिवंत राहणार नाही. म्हणजेच आपलं शरीर संपुष्टात येईल. जेनेटिक बदलांमुळे लोकांचं वय थोडं वाढू शकेल. मानव आपल्या जीवनाला हळूहळू पूर्ण करेल. कारण आजारपणं कमी होतील. आरोग्य चांगलं राहील. आजार संपुष्टात येतील. त्यामुळे आपण थोडे अधिक वर्षे जिवंत राहू.

जुन्या काळातील ऋषी-मुनींप्रमाणे मेंदूत एखाच्या संदेशाचा विचार करून तो मानव दुसऱ्यापर्यंत पोहोचवू शकेल. मात्र हे सिंथेटिक टेलिपथीच्या माध्यमातून घडेल. भविष्यात माहितीची देवाण घेणाव शब्दांमध्ये कमी तर इलेक्ट्रिकल सिग्नलच्या माध्यमातून अधिक होईल.

















